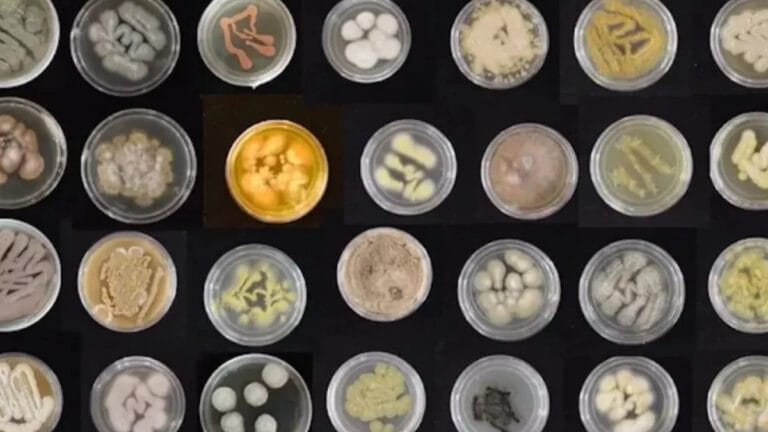
Bilim insanları, deniz mantarlarını plastikleri yemeleri için eğitiyor

--°C
Yükleniyor...
Konum belirleniyor...
Hava Kalitesi:
-- AQI
Ana Kirletici: --


Bursa’da dalgıçlar müsilajı görüntüledi
22 Şubat 2025


‘Hava ısındıkça müsilaj daha da artacak’
19 Şubat 2025


Türkiye’de tatlı su kaynakları tehlike altında
19 Şubat 2025


ASKİ’ye 5 milyon lira ceza
19 Şubat 2025
Son Haberler














Karbon Ayak İzi Hesapla
Günlük alışkanlıklarınızın çevreye etkisini öğrenin. Hemen hesaplayın!


Çevre Haber Bülteni
Haftalık çevre haberlerini ve özel makaleleri doğrudan e-posta kutunuza alın.


Son Depremler
Bölgenizdeki güncel depremleri anında görüntüleyin.
Çevreyi Keşfet,
Bilgini Test Et!
Bilgini Test Et!
Lorem ipsum dolor sit amet, consectetur adipiscing elit. Ut elit tellus, luctus nec ullamcorper mattis, pulvinar dapibus leo.